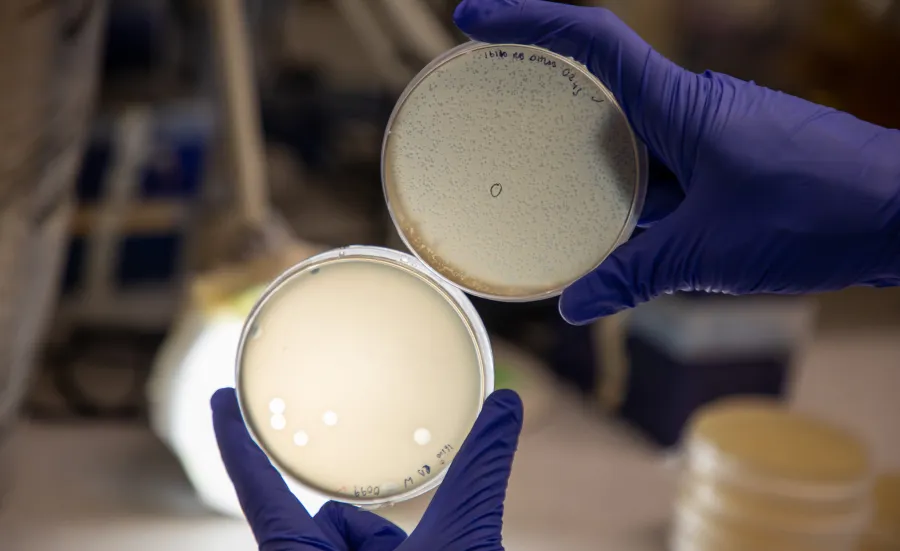
Two petri dishes held up by gloved hands, showing bacterial lysis by phages.

Child page cards
-
Research areas
Learn more about our microbiology research and areas of expertise. -
Our people
Meet the experts behind our microbiology research. -
Projects
Explore our current research projects. -
Publications
Browse our publications to learn more about our research. -
News
Read our latest research news and stories. -
Partnerships
Discover our collaboration and impact network.